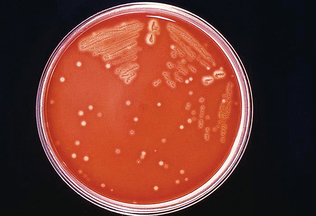
image
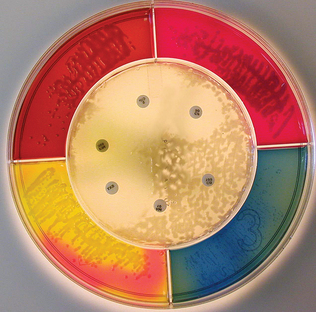
image

Diagnostic Microbiology
Microbiology refers to the study of microbes. Microbes are organisms that are too small to be seen with the unaided eye. Bacteria, fungi and viruses are all microbes. The study of these organisms is referred to as bacteriology, mycology, and virology, respectively. Virology evaluations in the veterinary clinical laboratory are usually performed with immunologic methods. Bacteria and fungi can be evaluated with a number of routine microbiology procedures. Although some practices send all microbiology work to a reference laboratory, most practices do some testing in-house. Bacterial and fungal samples can be collected quickly, easily, and inexpensively, and tests do not require much in the way of specialized equipment. Careful attention to quality control is vital to ensuring the diagnostic value of results.
Most microbes found on and in the body are nonpathogenic (i.e., normal flora). The intestinal and respiratory tracts, skin, and parts of the urinary and reproductive tracts all have known normal flora. Samples collected from some locations, such as the spinal column, blood, and the urinary bladder, should be free of normal flora. Microbes that are considered normal flora and nonpathogenic when found in one location can produce significant disease if in a site where they should not reside.
BACTERIAL CELL MORPHOLOGY
Identification of bacterial pathogens is the primary purpose of microbiology examinations. Bacteria are small prokaryotic cells that range in size from 0.2 to 2.0 μm. The bacteria most frequently studied in the laboratory range from 0.5 to 1 μm in width and 2 to 5 μm in length. Most cellular organelles are absent except cell walls, plasma membranes, and ribosomes. Some contain capsules and flagella and can develop endospores. Bacteria have specific requirements for temperature, pH, oxygen tension, and nutrition. These requirements must be considered when collecting and preparing microbiology samples. In addition, identification of some bacteria can be aided by using these characteristics. The majority of clinically significant bacterial species require a pH in the range of 6.5 to 7.5. Bacteria that require oxygen to survive are referred to as obligate aerobes. Bacteria that are killed in the presence of oxygen or whose growth is inhibited in the presence of oxygen are obligate anaerobes. Organisms referred to as facultative anaerobes can survive in the absence of oxygen but their growth is limited. Microaerophilic bacteria prefer reduced oxygen tension, and capnophilic bacteria require high levels of carbon dioxide.
Nutritional requirements vary among bacteria, and culture media types are chosen on the basis of these requirements. Some bacteria have strict requirements; these are referred to as fastidious microbes.
Temperature requirements also vary among different bacteria. However, nearly all bacteria that are pathogenic to animals grow best at 20° to 40° C and are referred to as mesophiles. Bacteria with lower and higher temperature requirements are referred to as psychrophiles and thermophiles, respectively.
Methods of identification are directed toward characterizing bacteria on the basis of a variety of criteria. These criteria include size, shape, arrangement, and chemical reactivity. These characteristics are often used in the differentiation of specific bacterial pathogens.
Bacteria may be organized into the following three groups according to their shape (Fig. 4-1):
1. Coccus (pl. cocci): spherical cells, such as Staphylococcus aureus, the causative agent of mastitis in animals.
2. Bacillus (pl. bacilli): shaped like rods or cylinders, such as Bacillus anthracis, the causative agent of anthrax in animals and human beings.
3. Spiral: usually occur singly and can be subdivided into loose spirals, such as Borrelia anserina, which causes avian borreliosis; tight spirals, such as Leptospira pomona, which causes red water disease in cattle; and comma-shaped spirals, such as Campylobacter fetus, a cause of abortion in cattle.
Bacteria are found in a variety of arrangements. Some grow as single cells and others remain attached after dividing and form chains or clusters. Many exhibit patterns of arrangement, such as the following, that are important for their identification (Fig. 4-2):
1. Single. Some bacteria occur singly, such as spirilla (singular, spirillum) and most bacilli (singular, bacillus).
2. Pairs. Some bacteria occur in pairs, such as Streptococcus pneumoniae (diplococcus).
3. Clusters or bunches. Some bacteria occur in clusters, bunches, or groups. For example, Staphylococcus aureus forms grapelike clusters.
4. Chains. Some organisms grow in short or long chains, such as the Streptococcus species.
5. Palisades. Some organisms can be arranged in a palisade or “Chinese letter” pattern, such as Corynebacterium species.
With pleomorphic organisms, such as Corynebacterium species, judging whether the organism is a coccus or a bacillus may be difficult. If the Gram-stained smear was made from a pure culture and any of the cells present are definitely rod shaped, the organism must be regarded as a bacillus for purposes of identification.
Spores
When cultured, a few genera of bacteria form intracellular refractile bodies called endospores or, more commonly, spores. Organisms in the genera Bacillus and Clostridium are spore formers. Bacterial spores are resistant to heat, desiccation, chemicals, and radiation.
Spores vary in size, shape, and location in the cell and may be classified as follows (Fig. 4-3):
• Central: present in the center of the cell, such as Bacillus anthracis
• Subterminal: present near the end of the cell, such as Clostridium chauvoei
• Terminal: present at the end or pole of the cell, such as Clostridium tetani
Performing a special spore stain may not be necessary because the endospores can usually be visualized as nonstaining bodies in Gram stained samples.
BACTERIAL GROWTH
Bacterial cells contain a single DNA strand and reproduce primarily by binary fission. When bacteria colonize any media, such as living tissue or a culture plate in a laboratory, bacteria growth proceeds through four distinct phases (Fig. 4-4). The initial phase, referred to as the lag phase, represents the time during which the bacteria are adapting their metabolism to use the resources on their new media. Assuming the media contains the appropriate growth factors and conditions for the particular bacterial species, the lag phase is followed by the exponential growth phase. The rate of growth during this phase is often referred to as the doubling time or generation time. The generation time is variable with different species and under different environmental conditions. The exponential growth phase continues until essential nutrients are depleted, toxic waste products accumulate, and/or space becomes limiting. The colony then enters the stationary phase, representing the time during which the total numbers of cells show no net increase or decrease. The length of this phase is also variable among different bacterial species. The final phase is the logarithmic decline phase, or death phase. The rate of death is not necessarily the same as the rate of initial growth. Spore formation usually occurs during this phase.
EQUIPMENT AND SUPPLIES
Ideally the practice facility should have a separate room away from the main traffic areas of the clinic for microbiologic procedures. The room must have adequate lighting and ventilation; a washable floor and limited traffic; at least two work areas, one for processing the samples and one for culture work, with smooth surfaces that are easily disinfected; electrical outlets; ample storage space; and easy access to an incubator and a refrigerator.
Laboratory Safety
Most of the microorganisms encountered in the microbiology laboratory are potentially pathogenic. All specimens should be treated as potentially zoonotic. The safety of every person working in the laboratory depends on strict observance of rules. Aseptic technique is always observed when transferring or working with infectious agents or specimens.
Veterinary technicians must wear personal protective equipment when handling patient specimens, including a clean, long-sleeved, knee-length, white laboratory coat to prevent contamination of street clothes and dissemination of pathogens to the general public. Disposable gloves are always worn in the microbiology laboratory, and face masks may be needed if production of aerosol particles is likely. Laboratory coats should be washed at least weekly in hot water and strong bleach. If the coat becomes soiled during daily diagnostic procedures, it is removed immediately and placed in the receptacle designated for dirty linens. All laboratory coats should be washed together. At no time should laboratory coats be mixed with other laundry from the veterinary clinic or with laundry from outside the laboratory. All personal protective equipment should be removed before leaving the laboratory. The veterinary technician must wash his or her hands thoroughly before leaving the laboratory.
Materials contaminated with potentially infectious agents must be decontaminated before disposal.
Scissors, forceps, and scalpel blade holders can be sterilized in an autoclave. Potentially hazardous materials (plates, test tubes, slides, pipettes, and broken glass) are placed in appropriate containers for disposal. If these materials must be discarded in the trash receptacles, they must first be autoclaved to eliminate any infectious agents. Bench tops are cleaned with disinfectant (70% ethanol or dilute bleach solution) at the beginning and end of the work period. Spilled cultures are treated with disinfectant and allowed contact for 20 minutes before they are cleaned up. The surfaces of all other equipment, such as incubators and refrigerators, should be wiped down with disinfectant on a daily basis. Nondisposable wire loops contaminated with microbes must be flamed immediately after use.
Eating, drinking, smoking, handling contact lenses, and applying cosmetics are not permitted in the laboratory. Appropriate signage should state this rule. Persons who wear contact lenses in the laboratory also should wear goggles or a face shield. Long hair must be tied back or tucked inside the laboratory coat. Labels should be moistened with water, not with the technician’s tongue. No food is stored in the laboratory; instead it is stored outside the laboratory in designated cabinets or refrigerators.
All accidents must be reported promptly to the laboratory supervisor or to the veterinarian.
Equipment and Supplies Needed for the Microbiology Laboratory
A good-quality incubator capable of maintaining constant temperature and humidity is the primary equipment needed in the microbiology laboratory. More information on incubators is available in Chapter 1. Supplies needed for collecting and preparing bacterial and fungal samples include the following:
• 3- to 20-ml syringes and 21- to 25-gauge needles
• Sterile endotracheal tube or jugular or urinary catheter
• Collection tubes and preservatives
• Rayon swab in transport media, such as Culturette (BD, Franklin Lakes, NJ) (Fig. 4-5)

Figure 4-5 The Culturette consists of a rayon swab in transport media. (Courtesy of B. Mitzner, DVM.)
• High-quality glass slides and cover slips
• Inoculating loops or wires, reusable metal or single-use disposable plastic (Fig. 4-6) and 10-μl calibrated loops
• Bunsen burner (natural gas or propane gas) or alcohol lamp (Fig. 4-7)
• A variety of culture media, including plates and broth
• Gram stain and other stains as needed
• Scissors, forceps, scalpel with blades (stored in 70% alcohol and flamed to sterilize)
• “Discard jar” containing disinfectant for contaminated instruments
• Wooden tongue depressors for handling fecal specimens
• Racks to hold tubes and bottles
• Refrigerator “cold packs” and polystyrene shipping containers for samples that must be sent to reference laboratories
Staining of Microbiology Samples
Two commonly used stains are Gram stain and acid-fast stain. Samples taken directly from patients are often Gram stained before the sample is cultured. Information obtained from a direct smear may help determine the suitability of the specimen for identification, the predominant organism in a mixed specimen, the appropriate medium for culture, and the appropriate antibacterials for sensitivity testing. Staining kits for Gram and Ziehl-Neelsen (acid-fast) stains are available commercially (Fig. 4-8). Commercially prepared staining solutions may require filtering if a precipitate forms. Simple stains, such as crystal violet or methylene blue, are typically used for yeasts. Lactophenol cotton blue stain is used to confirm the identity of fungal organisms. Many other types of stains are available for microbiology but most are performed only in large reference or research laboratories.
Gram Stain
Gram staining is used to categorize bacteria as gram positive or gram negative on the basis of cell wall structure. Gram stain kits contain solutions of crystal violet, Gram’s iodine (a decolorizer), and basic fuchsin or safranin.
Procedure: The sample should be applied thinly on the slide. Swab specimens may be rolled lightly onto the slide. Touching the sterile wire to one colony on the plate is usually sufficient to obtain enough bacteria for application to the slide. The colonies should be young (24-hour culture) because older colonies may not yield proper results, and the stained bacteria often become excessively decolorized.
Bacterial samples from plates are gently mixed in a drop of water or saline on the slide. If the sample is obtained from inoculated broth, two to three loopfuls are spread onto the slide. A sample also may be smeared directly onto a slide, such as from tissue or an abscess. Regardless of how the specimen is transferred onto the slide (swab, pipette, wire), care must be taken not to destroy the organisms.
The sample droplet on the slide may be encircled by using a wax pencil to help find the area after staining. After the material has dried on the slide, it is heat fixed by passing the slide through a flame two or three times, specimen side up. The technician should be careful to not overheat the slide. The temperature may be tested on the back of the hand. The slide should feel warm but not hot. Heat fixing prevents the sample from washing off, helps preserve cell morphology, and kills the bacteria and renders them permeable to stain.
The Gram staining procedure is as follows:
• The slide is placed on a staining rack over a sink.
• Crystal violet solution is poured onto the smear and allowed to sit 30 seconds.
• The slide is rinsed gently with water (tap water is acceptable).
• Iodine solution is poured onto the smear and allowed to stand for 30 seconds.
• The slide is rinsed gently with water.
• The smear is washed with decolorizer until no more purple color washes off (usually 10 seconds or less).
• The slide is rinsed with water and replaced on the rack.
• Basic fuchsin or safranin is poured onto the smear and allowed to stand for 30 seconds.
• The smear is rinsed with water.
• The smear is air dried or blotted between sheets of paper towel.
• The smear is examined microscopically with the 100× oil-immersion lens.
Interpretation: Bacteria that retain the crystal violet-iodine complex and stain purple are termed gram positive (Fig. 4-9). Those that lose the crystal violet or purple color and stain red by safranin or basic fuchsin are classified as gram negative (Fig. 4-10). The morphology of the bacteria on the smear also is important to note.

Figure 4-9 Typical staining pattern of gram-positive Actinomyces bacteria. (Courtesy Public Health Image Library, PHIL#6711, William A. Clark, Atlanta, 1977, Centers for Disease Control and Prevention.)

Figure 4-10 Typical staining pattern of gram-negative Yersinia bacteria. (Courtesy Public Health Image Library, PHIL#6711, Atlanta, 1980, Centers for Disease Control and Prevention.)
Determining the Gram stain reaction is an important step in the identification process. Performing the procedure properly and interpreting the results correctly require practice. To ensure proper staining quality, known (control) gram-positive and gram-negative organisms should be stained at least once a week and with each new batch of stain. These control organisms may be kept growing in the laboratory.
Potassium Hydroxide Test
Sometimes an organism may stain both gram positive and negative, which is called a gram-variable reaction. This may occur as a result of excessive decolorization, an overly thick smear, excessive heat fixation, old cultures, or poor quality of stain.
If a gram-variable reaction occurs, a quick way to check the reaction is with the potassium hydroxide (KOH) test. The procedure is as follows:
1. A loopful (or two, if necessary) of 3% KOH solution is placed on a slide.
2. A generous quantity of surface growth is removed from the culture and transferred to the drop of KOH.
3. The specimen is stirred into the KOH drop with a loop; the loop is then lifted slowly and gently. After a maximum of 2 minutes of stirring (usually 30 seconds), gram-negative organisms develop a mucoid appearance and produce a sticky strand when the drop is lifted with the loop. If the organisms are gram positive, the mixture stays homogeneous and does not form a strand on lifting.
4. The reaction is recorded as gram negative (sticky strand and mucoid mass formed) or gram positive (no sticky strand or mucoid mass formed).
Acid-Fast Stain
This stain is primarily used to detect Mycobacterium and Nocardia species. Numerous types of acid-fast stains are available, and some are not configured for easy use in the veterinary practice laboratory. Acid-fast stains contain several solutions, including a primary stain, typically dimethyl sulfoxide (DMSO) and carbol fuchsin; an acid-alcohol decolorizer; and a counterstain such as methylene blue. The slide is air dried and heat fixed by passing the slide, specimen side up, through a flame. The primary stain is used to flood the slide. The slide is then heated over the flame until the stain steams. The slide is cooled for 5 minutes and then rinsed with tap water. Acid alcohol is used to decolorize the slide for 1 to 2 minutes until the red color is gone, and the slide is rinsed again. The counterstain is added and then the slide rinsed with water and dried. Agents such as DMSO included in the initial staining procedure allow the stain to penetrate stain-resistant cells such as Mycobacterium. Subsequent addition of acid alcohol removes the stain. If the stain is not removed, the organism is “acid-fast” and appears red, whereas non-acid-fast microorganisms stain blue (Fig. 4-11).
Giemsa Stain
Giemsa stain is used to detect spirochetes and rickettsiae and demonstrate the capsule of Bacillus anthracis and the morphology of Dermatophilus congolensis. The smear is fixed in absolute methanol for 3 to 5 minutes and air dried. It is then dipped in diluted stain for 20 to 30 minutes. The staining time may be extended as indicated by results. For Borrelia anserina, the smear is gently heated while it is covered with Giemsa stain and stained for 4 to 5 minutes. The smear is then rinsed, air dried, and examined for the purplish-blue-stained bacteria.
Specialized Stains
Flagella stains, capsule stains, endospore stains, and fluorescent stains are also available but have limited application in the average veterinary practice laboratory. Fluorescent stains tend to be quite expensive and are used primarily for the identification of Legionella and Pseudomonas. Flagella stains usually contain crystal violet and are used to detect and characterize bacterial motility. These tend to be somewhat expensive for the small veterinary practice laboratory. Other methods that can be used to test motility include the hanging drop preparation and the use of motility test media. Capsule stains are used for detection of pathogenic bacteria. All bacteria that contain capsules are pathogenic. However, not all pathogenic bacteria contain capsules. Capsule stains often require the use of a bright-field phase contrast microscopy.
Bacterial spores contain protein coats of keratin that are resistant to most normal staining procedures. Endospore stains detect the presence, location, and shape of spores and can aid in differentiation of bacteria. Endospore staining is done on an older culture (more than 48 hours) because spore formation occurs during the logarithmic decline phase. The procedure involves addition of malachite green to the specimen on the slide and then heating the slide. The slide is washed and counterstained with safranin or basic fuchsin. Spores appear dark blue/green, with the remainder of the bacterial cell pink or red (Fig 4-12). Spores may also be found free from cells.
CULTURE MEDIA
Culture medium (pl. media) is any material, solid or liquid, that can support the growth of microorganisms. For bacteriology, culture media may be purchased as dehydrated powder or as prepared agar plates or ready-to-use liquid media for biochemical tests. All the commonly used media may be obtained already prepared from supply houses. Large reference and research laboratories may prepare and sterilize their own media from dehydrated powder. Solidifying agents used in preparing solid media include agar and gelatin. Agar is a dried extract of sea algae known as agaraphytes. Gelatin is a protein obtained from animal tissues.
For maximum life, agar plates should be kept refrigerated at 5° to 10° C. Plates must be kept away from the internal walls of the refrigerator because contact with the jacket can freeze and ruin the media.
Types of Media
Six general types of culture media are available: transport media, general purpose media, enriched media, selective media, differential media, and enrichment media. Some culture media contain characteristics of more than one type. General purpose media, sometimes referred to as nutrient media, is not commonly used in veterinary practice. Enriched media are formulated to meet the requirements of the most fastidious pathogens. They are basic nutrient media with extra nutrients added, such as blood, serum, or egg. Examples include blood agar and chocolate agar. Selective media contain antibacterial substances, such as bile salts or antimicrobials, which inhibit or kill all but a few types of bacteria. They facilitate isolation of a particular genus from a mixed inoculum. MacConkey agar is a type of selective media. Differential media allow bacteria to be differentiated into groups by biochemical reactions on the medium. Simmons citrate is a differential medium. Enrichment media are liquid media that favor growth of a particular group of organisms. They contain nutrients that either encourage growth of the desired organisms or contain inhibitory substances that suppress competitors. Examples include tetrathionate broth and selenite broth. Transport media are designed keep microbes alive while not encouraging growth and reproduction. The Culturette used for specimen collection contains prepared transport media. More specific details on some of the commonly used culture media are presented next. This is not meant to be an all-inclusive list; dozens of additional types of media are available. However, many of those not included subsequently are found only in large reference or research laboratories.
Blood Agar
This enriched medium supports the growth of most bacterial pathogens. Although several types of blood agars are available, trypticase soy agar with sheep blood is the most commonly used type. Blood agar acts as an enrichment medium and a differential medium because four distinct types of hemolysis can be detected on blood agar, as follows:
• Alpha hemolysis: partial hemolysis that creates a narrow band of greenish or slimy discoloration around the bacterial colony (Fig. 4-13)
Figure 4-13 Alpha hemolysis of Streptococcus on blood agar. (Courtesy Public Health Image Library, PHIL#8170. Richard R. Facklam, Atlanta, 1977, Centers for Disease Control and Prevention.)
• Beta hemolysis: complete hemolysis that creates a clear zone around the bacterial colony
• Gamma hemolysis: hemolysis that produces no change in the appearance of the medium and no hemolysis around colonies
• Delta hemolysis: also called double-zone hemolysis, a zone of hemolysis surrounded by a narrow zone of hemolysis around a bacterial colony
MacConkey Agar and Eosin-Methylene Blue Agar
MacConkey and eosin-methylene blue (EMB) agars are selective and differential media. MacConkey agar contains crystal violet (which suppresses growth of gram-positive bacteria), bile salts that are selective for lactose-fermenting Enterobacteriaceae, and a few other bile salt-tolerant gram-negative bacteria. Growth or no growth on MacConkey agar may be used as a test for primary identification of gram-negative genera. EMB media performs the same function and may also be used to identify lactose-fermenting organisms.
The indicators in MacConkey agar are lactose and neutral red. Lactose-fermenting organisms, such as Escherichia coli and Enterobacter and Klebsiella species produce acid from lactose and grow as pinkish-red colonies on this medium. Bacteria that cannot ferment lactose attack the peptone in MacConkey agar, producing an alkaline reaction and colorless colonies. Clinical specimens for routine isolation usually are cultured separately on both blood and MacConkey agars. Examination of both blood and MacConkey agar cultures, inoculated with the same clinical specimen, can yield considerable information. For example, no growth on the MacConkey agar plate but good growth on the blood agar plate suggests that the isolated pathogen is probably gram positive.
Thioglycollate Broth
Thioglycollate is a liquid medium used to culture anaerobic bacteria to determine the oxygen tolerance of microbes. The medium contains a stable oxygen gradient, with high concentrations of oxygen near the surface of the agar and anaerobic conditions near the bottom.
Obligate aerobes will grow only in the oxygen-rich top layer, whereas obligate anaerobes will grow only in the lower part of the tube. Facultative anaerobes can grow throughout the medium but will primarily grow in the middle of the tube, between the oxygen-rich and oxygen-free zones. The primary use of thioglycollate broth in veterinary practice is as an enrichment media and for blood cultures.
Urea Tubes
Urea slants are streaked with inoculum and incubated overnight at 37° C. Urea medium is a peach color. If the bacteria hydrolyze the urea in the medium, ammonia production turns the medium to a pink color. A negative result produces no color change (Fig. 4-14).
Sulfide-Indole Motility Tubes
The tube of sulfide-indole motility (SIM) medium is inoculated with a straight stab to a depth of approximately 1 inch. Care is taken to withdraw the wire out along the same line as on entry. Hydrogen sulfide production is indicated by blackening of the medium. Indole production requires the addition of 5 drops of Kovac’s reagent to the top of the medium. If tryptophan has been broken down to indole by the bacteria in the tube, a red ring immediately forms on top of the medium.
Simmons Citrate Tubes
Simmons citrate medium differentiates bacteria according to their use of citrate. Only the slant surface is inoculated. If bacteria use the citrate in the medium, a deep blue color develops. The unchanged medium is green.
Triple Sugar Iron Agar
Triple sugar iron agar medium is used for presumptive identification of salmonellae and initial differentiation of enteric bacteria. The media contain an indicator system for hydrogen sulfide production and a pH indicator, phenol red, that colors the uninoculated medium red. All Enterobacteriaceae ferment glucose, and the small amount (0.1%) is attacked preferentially and rapidly. At an early stage of incubation, both slant and butt turn yellow as a result of acid production. However, after the glucose is metabolized under aerobic conditions, and if the organism cannot ferment lactose or sucrose, the slope reverts to the red (alkaline) condition. The butt, under anaerobic conditions, remains yellow (acidic) (Fig. 4-15). To allow this reaction, the triple sugar iron agar always must be used in tubes with loose caps or plugged with sterile cotton.

Figure 4-15 Triple sugar iron agar is used to classify bacteria according to their ability to ferment glucose, lactose, or sucrose, as well as produce hydrogen sulfide. A yellow result indicates fermentation; the reddish result indicates no fermentation. (Courtesy Public Health Image Library, PHIL#6710, Atlanta, 1976, Centers for Disease Control and Prevention.)
If the organism can ferment lactose and/or sucrose in addition to the glucose, the lactose and sucrose are then attacked with resulting acid production, and the medium turns yellow (acidic) throughout. Lactose and sucrose are present in 1% quantities to maintain acidic conditions in the slant, which remains yellow. With organisms that produce hydrogen sulfide, blackening of the medium is partly superimposed on the other reactions. The triple sugar iron slants should be read after about 16 hours’ incubation at 37° C. After longer incubation, the blackening tends to reach the bottom of the tube and obscures the yellow butt.
The following summarizes the reactions of Salmonella species in triple sugar iron agar:
• Alkaline (red) slant and alkaline (red) butt: none of the sugars attacked
• Alkaline (red) slant and acidic (yellow) butt: glucose fermentation only
• Acidic (yellow) slant and acidic (yellow) butt: glucose attacked in addition to lactose and/or sucrose
• Blackening along stab line and through medium: hydrogen sulfide production
The triple sugar iron slant is stab inoculated with a single colony from the selective medium with a straight inoculating wire. The wire is pushed down to the bottom of the agar and, on withdrawing the wire, the agar slant is streaked. The inoculating wire still contains enough bacteria to inoculate a tube of lysine decarboxylase broth. During the search for salmonellae, at least two suspicious colonies should be individually tested in triple sugar iron agar per brilliant green plate. The triple sugar iron tubes should be incubated, with loose caps, at 37° C for 16 to 24 hours.
Brain-Heart Infusion Broth
Brain-heart infusion broth is a useful, general-purpose broth used to increase the number of organisms (preenrichment) before they are plated on solid medium. The broth is inoculated with the patient sample and subcultures taken as needed for additional testing.
For culture of blood samples, approximately 1 ml of the patient’s blood sample is added to nutrient broth or a special blood culture medium, which can be obtained commercially. Because a patient’s blood contains many substances inhibitory to bacteria, adding the blood sample directly to broth dilutes the effect of these natural inhibitors.
Mannitol Salt Agar
Mannitol salt agar is not routinely used but is a highly selective medium for staphylococci and could be used to isolate Staphylococcus aureus from contaminated specimens. The medium has a high salt content (7.5%) and contains mannitol and the pH indicator phenol red. Staphylococci are salt tolerant. S. aureus, but usually not S. epidermidis, ferments mannitol. The resulting acid turns S. aureus colonies and the surrounding medium yellow.
Bismuth Sulfite Agar
In this selective medium, freshly precipitated bismuth sulfite acts with brilliant green to suppress growth of coliforms while permitting growth of salmonellae. Sulfur compounds provide a substrate for hydrogen sulfide production. The metallic salts in the medium stain the colony and surrounding medium black or brown in the presence of hydrogen sulfide.
Atypical colonies may appear if the medium is heavily inoculated with organic matter. This situation may be prevented by suspension of the sample in sterile saline and use of the supernatant for inoculation.
The freshly prepared medium has a strong inhibitory action and is suitable for heavily contaminated samples. Storing the poured plates at 4° C for 3 days causes the medium to change color to green, making it less selective with small numbers of salmonellae being recovered.
The following summarizes the typical appearance of the more important bacterial organisms on bismuth sulfite agar and the appearance of their colonies:
• Salmonella typhi: black “rabbit eye” colonies, with surrounding black zone and metallic sheen after 18 hours; uniformly black after 48 hours’ incubation
• Other Salmonella species: variable colony appearance after 18 hours (black, green, or clear and mucoid); uniformly black colonies seen after 48 hours, often with widespread staining of the medium and a pronounced metallic sheen
• Other organisms (coliforms, Serratia, Proteus species): usually inhibited but occasionally dull green or brown colonies with no metallic sheen or staining of surrounding medium
Mueller-Hinton
Mueller-Hinton is a general purpose media primarily used for the performance of the agar diffusion antimicrobial sensitivity test. The chemical composition of the media does not interfere with the diffusion of the antimicrobials through the agar.
Sabouraud Dextrose and Bismuth-Glucose-Glycine-Yeast Media
Both of these media are used specifically for the culture of fungi and yeasts. Bismuth-glucose-glycine-yeast agar is commonly referred to as “biggy.” Dermatophyte test media found in most veterinary clinics is composed of Sabouraud dextrose agar and is commonly found in the veterinary practice.
Combination and Modular Culture Media
Several modular culture systems are available for use in the veterinary practice laboratory. The Bulls Eye (HealthLink, Jacksonville, FL) (Fig. 4-16) and Target (Troy Biologicals, Troy, MI) systems are five-chambered agar plates containing both selective and nonselective media plus a central area with Mueller-Hinton agar for sensitivity testing. “Dipslides” or “paddle” media such as Uri-Dip (Troy Biologicals) or Solar-Cult (Solar Biologicals, Ogdensburg, NY) (Fig. 4-17) are useful tools for urinary tract infection (UTI) screening. They consist of a two-sided agar paddle attached to the cap of a screw-top plastic tube. They are made with a variety of media combinations, although the most common ones have either MacConkey or EMB and cystine lactose electrolyte-deficient (CLED) agar. After incubation, a colony count is performed and the color of the CLED agar is compared with a chart for presumptive identification. Positive cultures that meet quantitation criteria for UTI should be sent to an outside laboratory for confirmation and susceptibility testing.

Figure 4-17 Solar-Cult media used for screening patients for urinary tract infections. (Courtesy Solar Biologicals, Ogdensburg, NY.)
Enterotubes (BD, Franklin Lakes, NJ) (Fig. 4-18) are one type of commercially available microbiology test kits that incorporate multiple types of media designed to provide differentiation of enteric bacteria on the basis of their biochemical reactions on the media. These tend to be relatively expensive and may not be financially justified unless large numbers of microbiology tests are performed on a variety of species.
Quality Control Cultures
Some cultures are required in a laboratory for quality control purposes. Various procedures and supplies must be monitored for quality and accuracy, including antibacterial susceptibility tests, media, biochemical tests, and certain tests for identification, such as the zone of beta hemolysis around S. aureus for the cyclic adenosine monophosphate test. A selection of control organisms can be obtained on disks. Media not containing fermentable sugars, such as trypticase soy agar, are suitable for maintaining fewer fastidious organisms, such as S. aureus and Enterobacteriaceae. The bacteria can be stab inoculated into a tube of medium and subcultured approximately every 2 months.
Streptococcus, Pasteurella, and Actinobacillus species die quickly on culture plates. Streptococci may be kept in a tube of cooked meat broth and subcultured approximately every 4 weeks. Pasteurella and Actinobacillus species remain viable if mixed with approximately 0.5 ml of sterile whole blood in a small tube and stored in a deep freeze at −10° C or lower. Otherwise these two genera should be subcultured on blood agar approximately every 3 days. Control cultures may be kept at room temperature in screw-capped tubes but preferably in a refrigerator at 4° C, which reduces the metabolic rate of the organisms.
SPECIMEN COLLECTION
Samples for microbiologic evaluation can be collected quickly, and most do not require specialized materials or equipment for proper evaluation. Specimens are collected by various methods, including aspiration, swabbing, and scraping. The specific techniques used depend on the type of lesion and its location on the animal’s body. Careful attention to aseptic technique is critical to achieving diagnostic-quality results. More details on sample collection techniques by aspiration, swabbing, and scraping can be found in Chapter 9.
The specific choice of collection method depends on the location of the lesion on the animal’s body, as well as the specific type of testing desired. Samples that are to be immediately processed can usually be collected by using sterile cotton swabs. However, this is the least suitable method of collection because contamination risk is high and cotton can inhibit microbial growth. Oxygen can also be trapped in the fibers, making recovery of anaerobic bacteria less likely. If delays in processing the sample are expected, a rayon swab in transport media (e.g., Culturette) must be used to preserve the quality of the sample. Aspirated samples can be collected by fine-needle biopsy.
The specimen selected must contain the organism causing the problem. Normal flora and contaminants may complicate sample collection and subsequent interpretation of results. Better results will be obtained if specimens are collected from sites that would normally be sterile because infections are likely to be caused by a single predominant organism. Good examples are urine (collected by cystocentesis) or intact skin pustules. Ears and fecal samples do not lend themselves well to in-house microbiology testing because of the number of commensal and secondary organisms that typically populate such exposed areas.
The following guidelines apply to proper specimen collection:
1. A complete history and sufficient clinical data must be obtained to help select procedures most appropriate to isolate organisms that may be present. Required data include the owner’s name, clinic name, address, and phone number. Species, name, age, sex, number of animals affected or dead, duration of the problem, and major signs observed also should be included. The tentative diagnosis, organism suspected, any treatment given, and type of laboratory investigation required should be included in the record.
2. The specimen must be collected aseptically. Specimen contamination is the most common cause of diagnostic failure. The importance of aseptic collection of microbiologic specimens cannot be overemphasized. Samples should be collected as soon as possible after the onset of clinical signs.
3. Multiple specimens must be kept separate to avoid cross-contamination. This practice is essential for intestinal specimens because of the flora normally present there.
4. The specimen container is labeled, especially if a zoonotic condition is suspected, such as anthrax, rabies, leptospirosis, brucellosis, or equine encephalitis. Tissues in suspected zoonoses should be submitted in a sealed, leak-proof, unbreakable container.
5. Adequate time should be taken. Obtaining results quickly at the expense of accuracy is counterproductive.
Table 4-1 summarizes sample collection guidelines for microbiology specimens.
PRIMARY IDENTIFICATION OF BACTERIA
Procedure 4-1 shows the typical sequences used in processing microbiologic specimens.
A systematic approach is needed in the identification of pathogenic bacteria. The practice laboratory should develop flow charts for use in the clinic that represent the bacteria seen most often and the tests used to differentiate those bacteria. Figure 4-19 is an example of a flow chart that can be used for differentiation of microbes. Specimens are first streaked onto a primary medium, such as blood agar and MacConkey agar. The plates are incubated for 18 to 24 hours and then examined for growth. Suspected pathogens on the incubated plate should be further identified regarding their genus and/or species by using the flow chart. With comparatively few tests, an organism may be identified to the genus level with a fair degree of certainty. Table 4-2 summarizes identifying characteristics of common bacterial pathogens in veterinary species. Table 4-3 summarizes bacterial pathogens of veterinary importance, species affected, resultant diseases or lesions, and specimens required for diagnosis. Appendix B, Bacterial Pathogens of Veterinary Importance, contains a summary of characteristics of and diseases produced by microbial pathogens seen in mammals and birds.
Most gram-positive and gram-negative organisms grow on blood agar. gram-positive organisms usually do not grow on MacConkey agar, but this agar supports growth of most gram-negative organisms. Selection of the colony from the routine blood agar plate is preferable rather than from MacConkey agar. The danger in subculturing from a selective medium such as MacConkey agar is that inhibited organisms may be present as microcolonies on the plate. One of these could inadvertently be the colony of interest.
Inoculation of Culture Media
Care must be taken to prevent contamination when inoculating media and handling the specimen. Aseptic (sterile) technique must be used at all times. Before obtaining samples from a cadaver or excised organs, sear the surface of the organ or tissue with a flamed spatula before it is cut open for sample collection. Culture plates are kept closed unless inoculating or removing colony specimens for testing. When transferring samples from or to a tube, pass the tube neck through a flame before and after transfer of material and avoid putting down the cap. Instead, the cap is held between the last two fingers. When flaming an inoculation loop or wire, place the near portion of the wire in the flame first and then work toward the contaminated end. Placing the contaminated end into the flame first could result in splattering of bacteria, causing aerosol contamination. When the specimen collected is a liquid, a small quantity of well-mixed samples is inoculated at the edge of the plate with a sterile swab or bacteriologic loop. Some laboratories use presterilized glass rods for streaking samples because Bunsen burners are not always available and glass rods are can be autoclaved. Disposable inoculating loops and wires are also available. If the specimen has been initially collected on a sterile swab, this is streaked directly onto the plate.
Streaking Culture Plates
The preferred method of streaking an agar plate is the “quadrant” streak method (Procedure 4-2 and Fig. 4-20). In Figure 4-20, area A is the primary streak or “well” of the plate. The bacteriologic loop may or may not be flamed and cooled before making streaks B, C, and D. This depends on the estimated number of bacteria present in the specimen. The use of two loops, one of which is flamed and cooling while the other is being used, is a practical technique.

Figure 4-20 Quadrant streak method for isolation of bacteria. (From McCurnin DM, Bassert JM: Clinical textbook for veterinary technicians, ed 6, St Louis, 2006, Saunders.)
Each streaked area is overlapped only once or twice to avoid depositing excessive numbers of bacteria in an area. Otherwise, the resultant colonies are not discrete and isolated. Isolated colonies typically grow in area D of the plate. The use of the entire plate is important, keeping the streak lines close together to include as many streaks as possible and taking care not to overlap the other streak lines. If several types of colonies grow on the plate, each colony is subcultured onto separate plates and the procedure repeated until a pure culture is obtained.
Inoculation of Slants
If agar slants are used, only the surface of the slant may be inoculated, or the butt and the surface may be inoculated. To inoculate only the surface of the slant, a straight flamed wire is used to obtain a colony of bacteria from the primary isolation plate. The surface of the slant is streaked in an S shape. To inoculate both the butt and slant, the butt of the slant is stabbed with the tip of the inoculating wire and then carefully withdrawn up the same insertion path. The surface of the slant is then streaked in an S shape (Procedure 4-3 and Fig. 4-21). Enough bacteria should be on the wire to inoculate the surface even after stabbing the butt. The tube’s cap should be replaced loosely.
Incubation of Cultures
For pathogens that can invade the internal organs of an animal, the optimal growth temperature is usually near 37° C. For some fish pathogens, skin pathogens (such as dermatophytes), and environmental organisms, the optimal growth temperature is lower. Care should be taken to maintain the incubator temperature at 37° C, which is the optimal temperature, because bacterial growth cannot occur above this temperature.
Incubation time depends on the generation time of individual bacterial species and the type of medium on which they are growing. For routine cultures, plates should be incubated for 48 hours, with plates examined after 18 to 24 hours of incubation. Organisms such as Nocardia species may take 72 hours before colonies are visible. The culture plates should be inverted during incubation so that moisture does not collect on the surface of the agar, which may cause clumping of colonies.
Some pathogens require carbon dioxide for growth in the culture atmosphere. A candle jar may be used for this purpose. The plates are placed in a large jar, a lit candle is put on top of the plates, and the jar is sealed. The candle flame soon dies, leaving a decreased amount of oxygen and increased carbon dioxide in the jar’s atmosphere. (This does not create an anaerobic condition.) The plates are incubated for 18 to 24 hours and then checked for growth. If no growth occurs, the plates are reincubated in the candle jar for another 18 to 24 hours and rechecked for growth. Larger laboratories may have incubators that automatically monitor temperature, carbon dioxide and oxygen levels, and humidity.
Colony Characteristics
An experienced technician can recognize several bacteria on the basis of gross observation of the colonies. Various colony characteristics, including the following, may help identify the bacterium involved (Fig. 4-22):
Culture of Anaerobes
Because most anaerobes survive exposure to air for less than 20 minutes, collection of samples for anaerobic culture on swabs is not acceptable. Preferred anaerobic specimens include blocks of tissue (2-inch-cube minimum) in a closed, sterile container, and pus and exudate collected in a sterile syringe, with the air expelled and the needle plugged with a rubber stopper or bent backward on itself. Specialized anaerobic specimen collection systems are also available.
Specimens should be cultured as soon as possible after collection. The specimen is inoculated onto a blood agar plate and into thioglycollate broth. The blood agar plates are put into an anaerobe jar, which provides an anaerobic environment during incubation. A self-contained system, such as a Gas Pack (Oxoid, Columbia, MD.) may be used.
Conditions in which isolation of anaerobes may be significant include soft-tissue abscesses, postoperative wounds, peritonitis, septicemia, endocarditis, endometritis, gangrene, pulmonary infection, and foot rot in cattle, sheep, and swine. The isolated anaerobe may be the sole etiologic agent or a partner in a synergistic relationship with another bacterium. For example, liver abscesses seen at slaughter in otherwise healthy feedlot cattle commonly yield the anaerobe Fusobacterium necrophorum and the aerobe Actinomyces pyogenes. For conditions involving Clostridium chauvoei, C. septicum, C. novyi, and C. sordellii, most laboratories use the fluorescent antibody technique in diagnosis. Specimens include affected muscle and a rib containing bone marrow.
Additional Bacterial Testing
Determining the genus of a pathogenic organism is often possible by using just the staining and culture characteristics. This is referred to as a presumptive or tentative identification. Often the presumptive identification gives the veterinarian enough information to develop a diagnostic and treatment plan. However, some organisms must be further differentiated to the species level and require additional testing for positive identification. A partial list of commonly performed tests follows.
Motility
Several methods are commonly used to test motility: the hanging drop prep, the wet prep, and motility media. For a wet prep, a young broth culture is used. A moderately heavy suspension of the bacterial sample is made in a few milliliters of nutrient broth incubated for 2 to 3 hours at room temperature. A loopful of this culture is placed on a microscope slide under a cover slip and examined with the high dry objective. If the bacteria are obviously motile, with individual cells moving backward or forward among other cells, the answer has been obtained. Brownian movement should not be mistaken for true motility. Brownian movement is the shifting of cells or particles, with little movement relative to each other.
Wet preps tend to evaporate rapidly under the microscope and some bacteria may not appear obviously motile unless provided with additional liquid. The hanging drop prep can eliminate these problems. Special slides are available that contain concave depressions in the center. The slide should be cleaned with alcohol and wiped dry. A small ring of petroleum jelly is placed around the concave area of the slide just before use. To prepare a hanging drop prep, place a drop of bacterial suspension on a cover slip and invert the cover slip onto the concave area of the slide. Press the cover slip down slightly so the petroleum jelly seals the concavity. The suspension will be left hanging upside down into the well of the concave slide. This preparation does not tend to dry out quickly and can be observed for a fairly long period.
If the organisms are nonmotile on microscopic examination, motility media should be used. Two tubes of a motility medium, such as SIM medium, are stab inoculated. One tube is incubated at 37° C and the other at room temperature for 24 to 48 hours. If growth is restricted to the stab inoculation line, the organism is nonmotile. Diffuse growth throughout the medium means the bacterium is motile. To interpret the results, the tubes are held against a good light and the inoculated tubes compared with an uninoculated one. The SIM medium is unsuitable for motility testing of organisms that produce hydrogen sulfide in this medium because the blackening that results may make the motility test difficult to read.
Catalase Test
The catalase test is performed on gram-positive cocci and small gram-positive bacilli. It tests for the enzyme catalase, which acts on hydrogen peroxide to produce water and oxygen. A small amount of a colony from a blood agar plate is placed on a microscope slide and a drop of catalase reagent (3% hydrogen peroxide) is added. If the colony is catalase positive, gas bubbles are produced. No bubble production indicates a negative result.
No blood agar should be transferred with the colony because blood agar can produce a slightly positive reaction. A positive reaction also may occur if a mixed colony is sampled, that is, one with both catalase-positive and catalase-negative organisms growing together. The plate must be carefully streaked to obtain isolated colonies. Staphylococci can be used as catalase-positive controls and streptococci as catalase-negative controls.
Coagulase Test
The coagulase test is performed on catalase-positive, gram-positive cocci. S. aureus produces coagulase, an enzyme that coagulates plasma. Two versions of the test are available: the slide coagulase test and the tube coagulase test. The coagulase test is used to differentiate between coagulase-positive S. aureus, S. intermedius, and coagulase-negative Staphylococcus, such as S. epidermidis or S. saprophyticus.
The tube coagulase test uses lyophilized plasma (purchased from a medical supply house) diluted according to the manufacturer’s directions. Approximately 0.5 ml is placed in a test tube and inoculated with a loopful of the organism cultured on a noninhibitory medium, such as blood agar. The tube is incubated at 37° C and read hourly for 4 hours. A negative reaction is indicated by no clot formation, whereas a positive reaction is indicated by clots. If the test result remains negative, the sample is incubated again for 24 hours and then read.
The slide coagulase test is a commercially available, rapid screening test that detects surface-bound coagulase or clumping factor. More than 95% of coagulase-producing staphylococci possess clumping factor. A loopful of staphylococci from a colony is first emulsified in a drop of water or saline solution to yield a thick suspension. A drop of fresh rabbit or human plasma is then added and stirred with a sterile loop. A positive reaction is indicated by clumping within 5 to 20 seconds.
Oxidase Activity
This test depends on the presence of cytochrome C oxidase in bacteria. A drop of 1% tetramethyl-p-phenylenediamine is added to a piece of filter paper in a Petri dish. The filter paper must be damp but not saturated. Prepared dry reagent slides are also available for performing the oxidase test and eliminate the need for reagent handling. A short streak of the sample is made on the filter paper or prepared slide using a glass rod or the end of a Pasteur pipette that has been bent into a hook. The sample should be applied with a gentle rubbing action. A nickel-chromium wire bacteriologic loop should not be used because any traces of iron may give a false-positive result.
In a positive test, the reagent is reduced to a deep purple color within 60 seconds. If the color-change reaction takes longer than this, the result should be regarded as negative. Oxidase reagent tends to be unstable and becomes discolored with time. It should be discarded if it becomes dark purple. Pseudomonas aeruginosa can be used as an oxidase-positive control and E. coli as an oxidase-negative control.
Acid Production from Glucose
A tube of 1% glucose in peptone broth, containing a pH indicator, is inoculated and incubated for 24 to 48 hours at 37° C. For fastidious organisms, such as Streptococcus species, approximately 5 drops of sterile serum should be added to the peptone water medium or growth may not occur.
ANTIBIOTIC SENSITIVITY TESTING
When bacteria are isolated from a patient, an antimicrobial sensitivity test may be performed to determine the susceptibility or resistance to specific antimicrobial drugs. The results of this test indicate which antimicrobial to use in treatment. Ideally, the specimen used for antimicrobial susceptibility testing is taken from the animal before treatment begins. The veterinarian may begin treatment before obtaining susceptibility results but then may change to a more appropriate drug when the results are available.
Agar Diffusion Method
The agar diffusion test is the most commonly performed method for antimicrobial susceptibility testing and uses paper disks impregnated with antimicrobials. It is quantitative and requires measurement of inhibitory zone sizes to give an estimate of antimicrobial susceptibility. The concentration of drug in the disk is chosen to correlate with therapeutic levels of the drug in the treated animal. Diffusion methods in common use include the U.S. Food and Drug Administration (FDA) method; standardized disk susceptibility method, which is a modified Bauer-Kirby technique; and the International Collaborative Study standardized disk technique. The most commonly used method of antibiotic susceptibility testing is the Kirby-Bauer.
A similar method can be used to determine the minimum inhibitory concentration (MIC) of an antimicrobial. This is the smallest concentration of the specific antimicrobial that can inhibit the growth of a given bacteria. Paper disks with varying concentrations of the chosen antimicrobial are placed on a freshly inoculated culture plate and incubated. Measuring the zones of inhibition around each of these disks will aid in choosing an appropriate concentration of medication to be given to the patient.
Although cultures can be performed in the classic manner by using individual Mueller-Hinton agar plates, modular culture systems or specialized media are more commonly used in the veterinary practice. Some organisms, such as streptococci, do not grow sufficiently well on plain Mueller-Hinton agar for a test to be read. In these cases, Mueller-Hinton agar plus 5% blood must be used. However, having departed from the standardized method, the inhibitory zone sizes must be interpreted with caution. For example, the zone sizes for novobiocin are smaller if the medium contains blood. Most streptococci are still susceptible to penicillin.
A supply of antibiotic disks is needed corresponding to the antibiotics commonly used in the clinic and the dosages most often needed. The antimicrobial content in a disk is indicated in Table 4-4. Only one disk representative each of the tetracyclines and one for the sulfonamides is necessary because of the phenomenon of cross-resistance. For example, if the bacterial species is resistant to one of the tetracyclines, it is usually resistant to all members of the group.
TABLE 4-4
Chart of Inhibitory Zones to Determine the Relative Resistance of the Bacterium to the Antibiotics Being Tested

*Ampicillin is used to test for susceptibility to amoxicillin and hetacillin.
†Cephalothin is used to test all first-generation cephalosporins, such as cephapirin and cefadroxil. Cefazolin should be tested separately with the gram-negative enteric organisms.
‡Clindamycin is used to test for susceptibility to clindamycin and lincomycin.
§Oxacillin is used to test for susceptibility to methicillin, nafcillin, and cloxacillin.
 Available as an infusion product for treatment of bovine mastitis during lactation.
Available as an infusion product for treatment of bovine mastitis during lactation.
¶Tetracycline is used to test for susceptibility to chlortetracycline, oxytetracycline, minocycline, and doxycycline.
**Trimethoprim/sulfamethoxazole is used to test for susceptibility to trimethoprim/sulfadiazine and ormetoprim/sulfadimethoxine.
Modified from National Committee for Clinical Laboratory Standards document M31-A2, Table 2, pp. 55-59, 2002., Reprinted from McCurnin DM, Bassert JM: Clinical textbook for veterinary technicians, ed 6, St Louis, 2006, Saunders.
Antimicrobial disks always should be kept in the refrigerator (4° C) when not being used and replaced as soon as possible after use. Outdated disks should never be used. The potency of the antimicrobial disks can be monitored with control organisms of known sensitivity patterns. A disk dispenser and a caliper or clear overlays for measuring inhibitory zones is also required. Disk dispensers should be obtained from the same manufacturer as the disks. Not all products are interchangeable. Inoculation of a thioglycollate or trypticase soy broth tube is recommended at the same time that plates are streaked. If the in-house culture results prove inconclusive, the broth culture can then be sent to an outside laboratory for confirmation.
Indirect sensitivity testing requires that colony samples be taken from the culture plate, subcultured in broth media, and incubated to achieve a turbidity that matches a standardized 0.5 McFarland suspension. The broth suspension is then applied to Mueller-Hinton media with a swab or loop to cover the plate evenly. To obtain the broth solution, just the surfaces of three or four colonies should be touched with a sterile loop. The loop should be placed in saline or broth to make a suspension. If bacteria are taken from just the surface of the colony, less likelihood exists of picking up an unseen contaminant growing at the base of the colony. More than one colony of a bacterial species always should be taken because a single colony may represent a variant that has a susceptibility pattern different from that of the parent strain. A correct density is an important aspect of getting reproducible results. The “lawn” of cells that grows after inoculation should be evenly distributed. Extremes in concentration must be avoided.
Application of undiluted samples, such as urine, directly to the Mueller-Hinton plate is referred to as direct sensitivity testing. Although not as precise as indirect testing, reasonable results can be expected when only one organism is present. Antibiotic susceptibility should be interpreted with caution when the culture shows multiple organisms.
The antimicrobial disks are placed on the inoculated agar surface with a disk dispenser or sterile forceps that have been flamed and cooled between each use. The disks should be no closer than 10 to 15 mm to the edge of the plate and sufficiently separated from each other to avoid overlapping of the zones of inhibition. Unless the disks were placed with a self-tamping dispenser, use a second sterile swab to gently press the antibiotic disks into the agar. The plates are incubated aerobically at 37° C and should be placed in the incubator within 15 minutes after placing the disks on the inoculated agar. Inoculated plates should be inverted before placing in the incubator to avoid condensation collecting on the surface of the agar. The plates should be kept in stacks of four or fewer because plates in the center of a tall stack take longer to reach incubation temperature.
Whether performed by the direct or indirect method, antibiotic susceptibility must be determined by physical measurement of the inhibitory zones (Fig. 4-23). That measurement is then compared with a chart of inhibitory zones to determine the relative resistance of the bacterium to the antibiotics being tested (see Table 4-4).
Reading the Zones of Inhibition
The plates should be read after a constant period, most satisfactorily after overnight incubation (18 to 24 hours). Prolonged incubation may alter the size of the zone of inhibition with antimicrobials that are not stable at 37° C or at best make the zones hard to read. If rapid results are imperative, the diameters of the zones of inhibition may be read after 6 to 8 hours’ incubation. These results should be confirmed by reading them again after overnight incubation. The diameter of each inhibition zone (including the diameter of the disk) is measured from the underside of the plate using calipers, a transparent ruler, or a template. The zones are measured and recorded to the nearest millimeter. If Mueller-Hinton agar with blood has been used, the zone size must be read from the top surface, with the lid of the plate removed.
Interpretation of Zone Sizes
Table 4-4 lists some of the commonly used antimicrobials and gives the suggested interpretation of zone sizes with the FDA standardized disk method. The zone sizes are divided into two major categories: resistant and susceptible to the particular antimicrobial agent. The latter category is subdivided into intermediate susceptibility and susceptible. For predictive purposes, a resistant organism is not likely to respond to therapy with the drug. A susceptible organism is susceptible to ordinary doses of the antimicrobial. Intermediate susceptibility implies that the organism is susceptible to ordinary doses when the drug is concentrated in the urine or tissues, or the antimicrobial may be used for treatment of systemic infections if a high dosage is safe.
The zone size alone is not indicative of the efficacy of an antimicrobial. Some drugs, such as vancomycin and colistin, do not readily diffuse through agar and give small inhibition zones, even when the test organism is fully susceptible. Therefore direct comparisons of zone diameter, produced by unrelated antimicrobials, are misleading and should not be made.
Control Organisms
Susceptible reference organisms, such as S. aureus, American Type Culture Collection (ATCC) 25923, and E. coli, ATCC 25922, should be tested regularly, preferably in parallel with each batch of antimicrobial susceptibility tests. These control organisms are used to check such factors as the growth-supporting capability of the medium, potency of antimicrobial disks, and other variable conditions that can affect results.
Limitations of the Test
The FDA method is designed for rapidly growing bacteria. Caution is needed for tests of anaerobes or slow-growing organisms for which the criteria for interpretation of zone diameters have not yet been established with certainty. In general, the zone diameters are somewhat larger for an equivalent minimal inhibitory concentration with slow-growing organisms than with rapid growers.
Some rare strains of staphylococci are resistant to methicillin and other penicillinase-stable penicillins. The routine test cannot be relied on to detect these strains, but they may be detected by incubation of an additional susceptibility test plate, containing a methicillin disk, at 30° C. A reduced zone diameter or no zone surrounding the methicillin disk on the plate incubated at 30° C is presumptive evidence of methicillin resistance.
COLONY COUNT
The presence of pathogenic bacteria does not necessarily indicate infection. For example, although normal urine is considered sterile, small numbers of organisms may occasionally be found even when collecting by cystocentesis. A colony count on cultured urine samples can help support a diagnosis of urinary tract infection. Colony counts can be performed by streaking a blood agar or other nonselective agar plate using a calibrated loop containing 10 μl of urine (Fig. 4-24). After incubation, all colonies are counted and multiplied by 100 to determine the number of colony-forming units (CFUs) per milliliter of urine. Although only a guideline, significant numbers of CFUs are more than 1000 for samples collected by cystocentesis and more than 10,000 for those collected by catheter. Voided samples, although not recommended for culture, should have more than 100,000 CFUs in dogs and 10,000 in cats to be deemed significant.

Figure 4-24 Procedure for inoculating media for semiquantitative bacterial colony counts when culturing urine. A, Primary inoculation with calibrated loop. B, Streak at right angles to previous streak. (Reprinted from McCurnin DM, Bassert JM: Clinical textbook for veterinary technicians, ed 6, St Louis, 2006, Saunders.)
CALIFORNIA MASTITIS TEST
Mastitis may be caused by bacterial or mycotic organisms. Several laboratory tests are available to diagnose mastitis, including the California mastitis test (CMT), somatic cell count, and milk culture. A quick check to detect bacteria can be performed by preparing a thin smear of mastotic milk. The smear is heat fixed and stained with Gram stain or methylene blue. The most common microorganisms involved with mastitis are S. aureus, Streptococcus agalactiae, Streptococcus uberis, E. coli, Corynebacterium species, and P. aeruginosa.
The CMT is a qualitative screening test that can be used as a “cowside” test. The test is based on gel formation when the test reagent reacts with DNA in somatic cells. As the cell count of the milk increases, the gelling action increases. Therefore the test provides an indirect measure of the cell count. The degree of gel formation is scored as negative, trace, 1, 2, or 3, and γ and +.
To perform the CMT, approximately 2 ml of milk is placed in each of the four cups on the CMT paddle and an equal amount of reagent is added. The paddle is gently rotated for approximately 10 seconds in a circular pattern to mix the milk and reagent. A score is then assigned for each quarter according to the chart of grading and interpretation (Table 4-5).
Precautions to be considered in this test are as follows:
1. DNA in somatic cells deteriorates upon standing. If the test is to be used as a laboratory test, the milk samples should be kept refrigerated, but not for more than 48 hours. Unrefrigerated milk cannot be tested accurately after about 12 hours.
2. White blood cells tend to migrate with milk fat. Therefore thorough mixing of samples just before testing is essential.
3. CMT reaction must be scored 10 to 15 seconds after mixing starts. Weaker reactions fade thereafter.
MILK CULTURE
Only positive milk samples identified by CMT or direct somatic cell count should be cultured. The milk sample is inoculated on blood agar and MacConkey agar and incubated at 37° C for 24 hours. Milk samples also are incubated simultaneously. If the cultures show minimal or no growth after 24 hours of incubation, a subculture is made on the blood and MacConkey agar plates from the incubated milk samples. The subcultured plates and the original culture plates are incubated for 24 hours at 37° C. A rapid but presumptive identification of the organism may be made on colonial morphologic characteristics, followed by confirmatory tests (e.g., triple sugar iron, lysine, SIM, methyl red, citrate, coagulase, and/or catalase).
IMMUNOLOGIC EXAMINATION
Numerous immunologic tests are available for identification of bacterial pathogens, particularly obligate intracellular bacteria. See Chapter 8 for more information on immunologic testing.
MYCOLOGY
Fungi are heterotrophs and may be parasitic or saprophytic. Most are multicellular, except yeasts. They contain eukaryotic cells with cell walls composed of chitin. Fungal organisms consist largely of webs of slender tubes, called hyphae, which grow toward food sources. Fungi digest their food externally, through release of digestive enzymes, then bring the resulting small molecules into the hyphae. Hyphae make up a branching web called a mycelium. Fungal organisms may also have a reproductive structure called a fruiting body that produces and releases reproductive cells called spores. Different groups of fungi produce different types of spores. Yeasts reproduce by budding rather than spore formation.
Most fungi rely on both sexual and asexual reproductive systems. Asexual spores produced by some fungi are either sporangiospores or conidia (Fig. 4-25). Sexual spores include ascospores, basidiospores, and zygospores (Fig. 4-26). Fungi can be differentiated on the basis of structure of the hyphae and on the presence of spores.

Figure 4-25 Sporangiospores and conidia, the two main types of asexual spores. (Courtesy Ashley E. Harmon. From Songer JG, Post KW: Veterinary microbiology: bacterial and fungal agents of animal disease, St Louis, 2005, Saunders.)

Figure 4-26 Sexual spores (zygospores, basidiospores, and ascospores) are produced through fusion of the protoplasm and nuclei of two cells by meiosis. (Courtesy Ashley E. Harmon. From Songer JG, Post KW: Veterinary microbiology: bacterial and fungal agents of animal disease, St Louis, 2005, Saunders.)
Pathogenic fungal organisms can be categorized into one of the following four groups on the basis of the type of reproductive structures present:
Supplies and Equipment
Supplies needed for collection and examination of fungal samples are much the same as those used for bacterial samples. Specifically, forceps, swabs, lactophenol cotton blue stain, potassium hydroxide solution, and culture media (DTM and/or Sabouraud agar). A Woods lamp may prove helpful, and cellophane tape may also be used to collect certain types of samples for fungal analysis.
Ideally a separate room and incubator should be used for fungal culture because fungal spores may contaminate plates used for bacteriologic culture. If an incubator is inadvertently contaminated with fungal spores, the interior should be swabbed thoroughly with 70% ethyl or isopropyl alcohol, or one bowl of water and one of alcohol should be placed at the bottom of the incubator and the incubator left empty of plates for 24 hours, with the door shut, at 37° C. Table 4-6 summarizes sample collection for mycology samples.
TABLE 4-6
Sample Collection for Fungal Testing
| Specimen | Container | Comments |
| Hairs | Paper envelope (dry conditions inhibit overgrowth of bacterial or saprophytic fungal contaminants) | Wash and dry affected area with soap and water. With forceps, epilate hairs from the periphery of an active lesion. Pull hairs in the direction of growth to include the root. Look for broken, stubby hairs, which are often infected. Useful for diagnosis of dermatophytosis. |
| Skin | Paper envelope | Clean skin with alcohol gauze sponge (cotton leaves too many fibers). Scrape the periphery of an active lesion with a sterile scalpel blade. Also obtain crusts and scabs. Useful for diagnosis of dermatophytosis. |
| Nails | Paper envelope | Proven nail infections in animals are rare. Cleanse affected nail with alcohol gauze. Scrape with a scalpel blade so that fine pieces are collected. Also collect debris under the nail. Useful for diagnosis of onchyomycosis. |
| Biopsy | Sterile tube in sterile saline or water | Normal and affected tissue should be included. Important to prevent specimen desiccation. |
| Urine | Sterile tube | Centrifuge and use sediment for direct examination and culture. Useful for diagnosis of histoplasmosis. |
| Cerebrospinal fluid | Sterile tube | Useful for diagnosis of cryptococcosis. Make India ink preparation to observe encapsulated yeasts. |
| Pleural/abdominal fluid | Sterile tube | If fluid contains flakes or granules, they should be included because these are actual colonies or organisms. |
| Transtracheal/bronchial washings | Sterile tube | Centrifuge and use sediment for direct examination and culture. Useful for diagnosis of systemic mycoses. |
| Nasal flush | Sterile tube | Centrifuge and use sediment for direct examination and culture. Useful for diagnosis of nasal aspergillosis and guttural pouch mycosis. |
| Ocular fluid | Sterile tube or syringe | Examine directly. Inoculate onto plated fungal media immediately after collection. Useful for diagnosis of ocular blastomycosis. |
From Songer JG, Post KW: Veterinary microbiology: bacterial and fungal agents of animal disease, St Louis, 2005, Saunders.
Most fungal agents of clinical importance in the veterinary practice are the cutaneous mycotic organisms, the dermatophytes. These organisms are often referred to as the ringworm fungi because of the characteristic circular lesions on the skin of infected animals. The dermatophytes are saprophytic mycelial-forming fungi that possess keratolytic properties that allow them to invade skin, nails, and hair. Some of these agents can infect human beings.
The dermatophytes comprise more than three dozen different organisms in the taxonomic genera Microsporum and Trichophyton. The most commonly seen species are Microsporum canis, M. gypseum, and Trichophyton mentagrophytes. Dermatophytes can be classified by the habitat in which they are most likely to be found: anthropophilic, confined to human beings; zoophilic, parasites of animals; and geophilic, normally existing as free-living saprophytes in the soil. Of the 15 known geophilic species, five may occasionally be opportunist pathogens, and only one, M. gypseum, commonly causes lesions in animals. These geophilic species pose a certain difficulty in diagnosis because they must be differentiated from zoophilic species.
Dermatophyte Testing
Most dermatophytes will grow on the outside of the hair shaft and in some cases can be visualized microscopically by mounting in 10% KOH or a combination of KOH and DMSO (DermatoPlate, Vetlab Supply, Palmetto Bay, FL.). The DMSO eliminates the need to warm the slide and provides more rapid clearing of the sample. To examine for dermatophytes, a few hairs plucked from the periphery of the suspect lesion are placed on a slide with 1 or 2 drops of the clearing solution. A cover glass is applied and the slide warmed gently if using just 10% KOH. After 2 to 10 minutes small globular arthrospores attached to the hair shafts are visible, indicating a positive test result.
A Woods lamp is an ultraviolet light source that may be used to screen suspect lesions for dermatophytes infection, but results may be ambiguous. Hair samples from dogs and cats, or the animals themselves, can be examined under the Woods lamp. Hairs infected with some species of Microsporum may fluoresce a clear apple-green under the Woods lamp in a darkened room. Approxi-mately 60% of positive cases involving Microsporum canis fluoresce, apparently depending on whether the fungus has reached the right growth stage to produce fluorescence. No fluorescence on Woods lamp examination does not rule out the possibility of ringworm infection.
Several products are available for culturing dermatophytes. The most common is standard dermatophyte test medium (DTM), which contains an indicator that turns red in the presence of most dermatophytes. Rapid sporulation medium (RSM) or enhanced sporulation media (ESM) with color indicators can be used in conjunction with standard DTM to accelerate the formation of macroconidia used for identification and confirmation. Standard Sabouraud dextrose agar will also promote earlier formation of macroconidia but contains no color indicator.
When collecting specimens for dermatophyte culture, clean the skin lesion to remove some of the surface contamination and collect specimens from the lesion periphery. Broken hair shafts and dry scale are most likely to contain viable organisms. Push the specimens into and partially below the surface of the media. Incubate the culture at room temperature with the cap or plate cover loosened and observe daily for growth. At the first sign of color change, perform a wet prep using Fungi-Tape (Scientific Device Laboratory, Des Plaines, IL.) or clear cellophane tape and lactophenol cotton blue stain to confirm the presence of pathogenic forms. Remember, the presence of red coloration (DTM) or teal (ESM and other media) alone is not diagnostic of dermatophyte infection. Both bacterial contaminants and nonpathogenic fungi can, under certain conditions, cause positive color reactions. Therefore a diagnosis must be supported by microscopic examination.
Fungal Cultures
Cultures of nondermatophytes are usually streaked out on blood agar or Sabouraud dextrose agar, as for bacteria. For fungal organisms that do not produce spores, cultures may be prepared by cutting 1 cm2 agar from the center of a Sabouraud dextrose agar plate with a sterile scalpel. A square of the same size is taken from the edge of the colony to be subcultured. This square is made to fit snugly into the hole in the agar. Taking material for subculture from the edge of a fungal colony is always advisable because the old mycelia at the center of the colony may not be viable.
Fungi that can invade tissue grow at body temperature (37° C). This temperature for incubation of primary cultures of nondermatophytes inhibits many contaminant saprophytic species. The exception to this is examination of specimens for dimorphic fungi, such as Blastomyces and Histoplasma species. These organisms grow as yeasts when at body temperature and as molds at 25° C. Cultures should be incubated, in parallel, at both temperatures. Characteristics of the systemic dimorphic fungi of veterinary importance are located in Table 4-7.
TABLE 4-7
Characteristics of the Systemic Dimorphic Fungi

Reprinted from Songer JG, Post KW: Veterinary microbiology: bacterial and fungal agents of animal disease, St Louis, 2005, Saunders.
Because many pathogenic fungi, such as Candida albicans and Aspergillus fumigatus, are ubiquitous, tissue sections showing invasion may be needed for definitive diagnosis of a mycotic infection. Occasionally, myceliate fungi or yeasts may appear on blood agar plates put up for bacteriology. These fungi or yeasts, of course, may be contaminants, but some of the original specimen, in 10% formalin, should be submitted for histopathologic examination. Examination of a KOH wet preparation for fungal elements is also useful. Table 4-8 summarizes the characteristics of common yeasts of veterinary importance.
TABLE 4-8
Characteristics of Yeasts of Veterinary Importance

From Songer JG, Post KW: Veterinary microbiology: bacterial and fungal agents of animal disease, St Louis, 2005, Saunders.
After incubation, cultures can be examined to identify the types of spores present. This is done by taking about 2.5 inches of clear cellophane tape and pressing the center of the tape, sticky side down, onto the center of the colony. The tape, with hyphae and fruiting heads adhering to it, is placed with the sticky side down on a microscope slide that has a drop of lactophenol cotton blue on it. The tape acts as its own cover slip. The slide preparation is examined under low power or high dry if necessary. Additional information on microscopic appearance of fungi is located in Table 4-9.
TABLE 4-9
Microscopic Appearance of Fungi in Clinical Specimens
| Disease | Microscopic Examination Method | Appearance |
| Aspergillosis | Wet mount (lactophenol cotton blue or KOH) | Septate hyphae with dichotomous branching; may see fruiting heads |
| Blastomycosis | Wet mount | Thick, double-walled budding yeasts with broad bases of attachment to mother cells |
| Candidiasis and other yeast infections | Wet mount | Budding and nonbudding yeasts; pseudohyphae may be present |
| Coccidioidomycosis | Wet mount | Spherules with and without endospores |
| Cryptococcosis | India ink | Encapsulated yeasts |
| Dermatophytosis | Wet mount | Hairs with arthrospores (endothrix or ectothrix), hyphae or sheath of spores around skin and nails |
| Histoplasmosis | Hematologic stain | Small yeasts with narrow necks of attachment to mother cells, often within macrophages |
| Mycetoma | Wet mount | Dark brown chlamydospores and hyaline hyphae in crushed granules |
| Phaeohyphomycosis | Wet mount | Dark hyphae |
| Pneumocystosis | Hematologic stain | Cysts and trophozoites |
| Protothecosis | Wet mount | Spherical to oval nonbudding, small and large cells containing two or more autospores |
| Rhinosporidiosis | Wet mount | Spherules (some large) with and without endospores |
| Sporotrichosis | Hematologic stain | Small oval to round to cigar-shaped yeasts |
| Zygomycosis | Wet count | Broad, relatively nonseptate hyphae |
From Songer JG, Post KW: Veterinary microbiology: bacterial and fungal agents of animal disease, St Louis, 2005, Saunders.
VIROLOGY
Virologic techniques are performed in specialized laboratories. They include histopathologic and serologic examination, electron microscopy, and attempted isolation and identification of the virus. The veterinary technician should contact the diagnostic laboratory to check which facilities are available, which samples are preferred, and whether a transport medium is necessary. If an exotic (reportable) disease is suspected, the proper authorities should be notified and no clinical material removed from the farm.
Many of the viral diseases encountered may be diagnosed on clinical and pathologic grounds. Serologic tests are available for most viral diseases. These usually require paired serum samples collected 2 to 3 weeks apart, early in the disease and on recovery. A rising antibody titer indicates recent infection by the virus. Collection of serum samples from contact animals is worth considering because these animals are more likely to have low initial titers to the virus.
Virus isolation is expensive and time-consuming and may provide only a diagnosis after the animals have recovered or died. However, in some instances isolation and identification of a virus should be attempted, such as to establish the identity of a viral disease not previously seen in a practice, discover the exact agent when serologic and other tests have given equivocal results, find the immunologic type of a virus in an epizootic, and verify the etiologic agent if a public health problem is involved.
Isolation of a virus from a diseased animal does not necessarily mean the virus caused the disease because many viruses can persist in animals without clinical signs of illness. Some other pathogen or condition could have been responsible for the disease. Virus isolation is most successful when specimens are collected early in the active infectious phase of the disease.
Viruses vary greatly in their ability to remain viable in tissues and exudates. Contamination with bacteria greatly decreases the success of attempted virus isolation. Specimens should be selected on the basis of their likelihood to contain large numbers of virus particles. They should be collected from live or very recently dead animals, even if this means sacrificing an affected animal. Samples for virology testing must be collected aseptically, kept at 4°C, and taken to a laboratory in the shortest time possible.
Collection of Specimens
Viruses are often present in the nasal or pharyngeal secretions early in the acute stage of respiratory diseases. Mucosal scrapings rather than swabs of the secretions should be taken. Sterile wooden tongue depressors are useful for mucosal scrapings. Attempted isolation from blood samples may be considered in generalized catarrhal diseases that tend to have a viremic stage. Poxviruses often may be demonstrated by electron microscopy in fluid from early vesicular lesions and sometimes in scabs from early lesions.
Specimens should also be selected for indirect studies, such as serologic, hematologic, histologic, and bacteriologic examinations. Viral diseases often are complicated by pathogenic bacteria acting as secondary invaders, which often can turn a mild viral infection into a serious disease. Specimens for histopathologic examination should consist of thin sections of tissue placed immediately in 10% formalin. Sections for histologic examination must never be frozen because this causes tissue artifacts that may be difficult to differentiate from a pathologic process.
Tissue samples for attempted virus isolation should be 2-inch cubes that contain both diseased and normal tissue, if possible. Mucosal scrapings should be obtained instead of swabs. Sterile screw-capped containers should be used for collection, with a separate container for each sample. Veterinary technicians must use strict aseptic technique and label the containers carefully.
Submission of Samples
Specimens should be refrigerated (4° C) when possible because virus titers decrease as temperature increases. If the specimens are to be delivered to the virology laboratory within 24 hours, they may be stored at 4° C and packed with coolant packs or ice in a polystyrene-insulated carton for shipment. If the time delay will be longer than 24 hours, snap freezing at −70° C and shipping on dry ice is desirable, except for specimens of suspected parainfluenza and influenza virus, in which case the integrity of these viruses is best preserved at −20° C. Specimens must be shipped in airtight containers to prevent entry of carbon dioxide into the container. Carbon dioxide gas from the dry ice can lower the pH of fluid, killing any pH-labile viruses.
Small pieces of tissue, fecal material, or mucus can be preserved in vials filled with 50% glycol and stored at 4° C. A virus transport medium is available commercially (NCS Diagnostics, Mississauga, ON, Canada). Because viruses vary in their longevity, a reference laboratory should be contacted for recommendations on the appropriate transport medium and sampling procedure.
Fecal materials and fluids often are submitted for electron microscopic examination. A fixative, such as universal or 10% buffered neutral formalin, should be added to the sample at a maximum of 1:1 fixative to sample to prevent overdilution of virus particles.
For urine samples, approximately 5 ml is sent in a sterile container. Virus transport medium should not be used. The specimen must be kept chilled if it is to arrive at the laboratory within 24 hours of collection; otherwise, it should be frozen at −270° C and shipped frozen.
If blood samples have been collected for serologic examination, they should be left at room temperature and the clot allowed to retract. Then they are refrigerated. Blood samples should not be frozen because freezing causes hemolysis and may render serum samples useless for serologic examination.
Cell Culture
To demonstrate the presence of a virus in a specimen, the virus is grown (isolated) in the laboratory, or the virus antigens or antibodies are assayed. Unlike bacteria, which can be grown on nutrient agar, viruses need living cells in which to grow and replicate. The tissue cells are placed into a suitable glass bottle or chamber containing a medium rich in nutrients. The cells settle and begin to grow in a confluent monolayer across the surface of the container. Various types of cells have been used for tissue culture of viruses. Most animal cells can be grown in vitro for some generations, but some cells divide indefinitely and are used for virus isolation. These cells are called continuous cell lines and are of a single type of cell. Continuous cell lines, such as those from fetal kidney, embryonic trachea, skin, and other cells, are derived from monkeys, dogs, cattle, pigs, cats, mice, hamsters, rabbits, and other animals. The virus specimen is commonly inoculated into a primary culture of cells derived from the same species of animal from which the specimen was taken.
After the cell culture has been inoculated with the virus specimen and incubated, it is examined. If the virus is present, cell damage may be visible as the virus particles invade the tissue cells. This damage is referred to as a cytopathic effect. Different types of cytopathic effects are used to identify viruses. Some viruses cause cell lysis, and others cause the cells to fuse and form syncytiae (sheets) and giant cells. An inclusion body is another type of cytopathic effect that may be seen.
Immunologic Examination
Clinical signs and cell culture examination may identify the virus to a family level and perhaps to the genus and species level, but definitive identification requires serologic procedures based on immunologic principles. Sometimes these serologic procedures may be used on the specimens directly, which saves the time and expense of cell culture. Chapter 8 contains more details on the immunologic tests used for detection of viral antigens and antibodies.
Recommended Reading
Anthony, A, Sirois, M. Microbiology, cytology, and urinalysis. In Sirois M, ed.: Principles and practice of veterinary technology, ed 2, St Louis: Mosby, 2004.
Hirsh DC, Walker RL, Maclachlan NJ, eds. Veterinary microbiology, ed 2, Ames, IA: Iowa State Press, 2004.
Latimer, KS, Prasse, KW, Mahaffey, EA. Duncan and Prasse’s veterinary laboratory medicine: clinical pathology. Ames, IA: Blackwell, 2003.
Songer, J, Post, K. Veterinary microbiology: bacterial and fungal agents of animal disease. St Louis: Saunders, 2005.